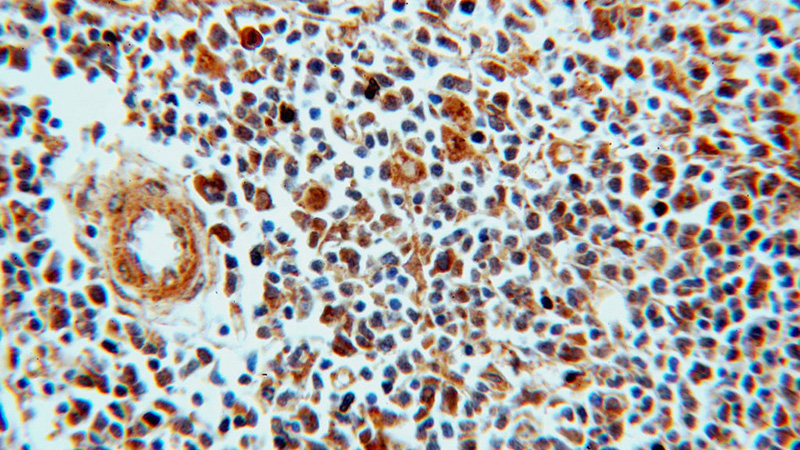
Immunohistochemical of paraffin-embedded human spleen using Catalog No:112191(LEF1 antibody) at dilution of 1:100 (under 40x lens)

-
Product Name
LEF1 antibody
- Documents
-
Description
LEF1 Rabbit Polyclonal antibody. Positive IHC detected in human thymus tissue, human spleen tissue. Positive IP detected in SW 1990 cells. Positive WB detected in COLO 320 cells, SW 1990 cells. Observed molecular weight by Western-blot: 40-45 kDa
-
Tested applications
ELISA, IHC, WB, IP
-
Species reactivity
Human,Mouse,Rat; other species not tested.
-
Alternative names
DKFZp586H0919 antibody; LEF 1 antibody; LEF1 antibody; TCF1 alpha antibody; TCF1ALPHA antibody
-
Isotype
Rabbit IgG
-
Preparation
This antibody was obtained by immunization of LEF1 recombinant protein (Accession Number: NM_016269). Purification method: Antigen affinity purified.
-
Clonality
Polyclonal
-
Formulation
PBS with 0.02% sodium azide and 50% glycerol pH 7.3.
-
Storage instructions
Store at -20℃. DO NOT ALIQUOT
-
Applications
Recommended Dilution:
WB: 1:200-1:1000
IP: 1:200-1:1000
IHC: 1:20-1:200
-
Validations

Immunohistochemical of paraffin-embedded human thymus using Catalog No:112191(LEF1 antibody) at dilution of 1:100 (under 40x lens)
Immunohistochemical of paraffin-embedded human spleen using Catalog No:112191(LEF1 antibody) at dilution of 1:100 (under 40x lens)

COLO 320 cells were subjected to SDS PAGE followed by western blot with Catalog No:112191(LEF1 Antibody) at dilution of 1:300

IP Result of anti-LEF1 (IP:Catalog No:112191, 4ug; Detection:Catalog No:112191 1:300) with SW 1990 cells lysate 2400ug.
-
Background
Lymphoid enhancer-binding factor 1(LEF1) belongs to a family of regulatory protein share homology with high mobility group protein-1, and it's a nuclear protein exprssed in pre-B and T cells. LEF1 has a role in the Wnt signaling pathway and hair cell differentiation and follicle morphogenesis. LEF1 exists as seven isoforms and we detects three isoforms with MW 40kDa, 35kDa and 30 kDa. Together with CTNNB1 and EP300, LEF1 activates transcription of target genes. Isoform 5 transcriptionally activates the fibronectin promoter, binds to and represses transcription from the E-cadherin promoter in a CTNNB1-independent manner, and is involved in reducing cellular aggregation and increasing cell migration of pancreatic cancer cells. Isoform 1 transcriptionally activates MYC and CCND1 expression and enhances proliferation of pancreatic tumor cells.
-
References
- Peng J, Lai ZG, Fang ZL. Dimethyloxalylglycine prevents bone loss in ovariectomized C57BL/6J mice through enhanced angiogenesis and osteogenesis. PloS one. 9(11):e112744. 2014.
- Gong Y, Xu CY, Wang JR. Inhibition of phosphodiesterase 5 reduces bone mass by suppression of canonical Wnt signaling. Cell death & disease. 5:e1544. 2014.
Related Products / Services
Please note: All products are "FOR RESEARCH USE ONLY AND ARE NOT INTENDED FOR DIAGNOSTIC OR THERAPEUTIC USE"
